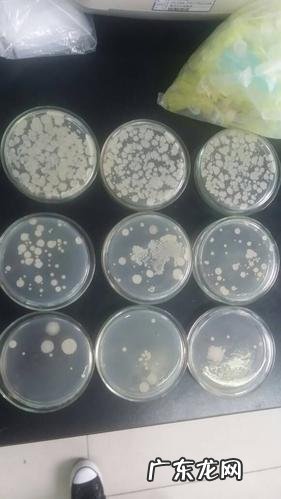

【培养皿染菌是什么情况】
文章插图
使用不当出现的染菌问题(细菌霉菌几率均等 , 多在培养基表面或琼脂和平皿的边缘)1、小包装使用剩余的暂存(冰箱或A级区域) 。2、拆包装在普通区传递窗一次性拆除三层包装的特殊案例 。3、拆包装时动作幅度过大 , 平皿散落 。4、上述两项中会出现特殊染菌现象 , 菌在平皿边缘生长 , 或延平皿与培养基缝隙生长的特例 。(这个通常和包装真空 , 气流倒吸相关) 。
- 培养皿为什么是圆形的
- 外公是什么关系
- 农村电商存在的问题及解决的对策分别是什么?
- 农村电商包括哪些方面?意义是什么?
- 千牛注销了怎么恢复?注销流程是什么?
- 拼多多先用后付退货还要付款吗?好处是什么?
- 花菜是什么菜
- hdr是什么拍照功能开还是不开
- 口蘑炒菜必备!最佳搭档是什么?
- 三颈烧瓶的作用是什么
特别声明:本站内容均来自网友提供或互联网,仅供参考,请勿用于商业和其他非法用途。如果侵犯了您的权益请与我们联系,我们将在24小时内删除。
